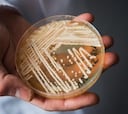

'Island of death'
They had no idea what was lurking beneath their feet


Health and Wellness
Looking to avoid kidney stones? You might need to put down the bottle



Alzheimer's disease
Diagnosed with Alzheimer’s at 41: “A fog comes over your brain”

Page3